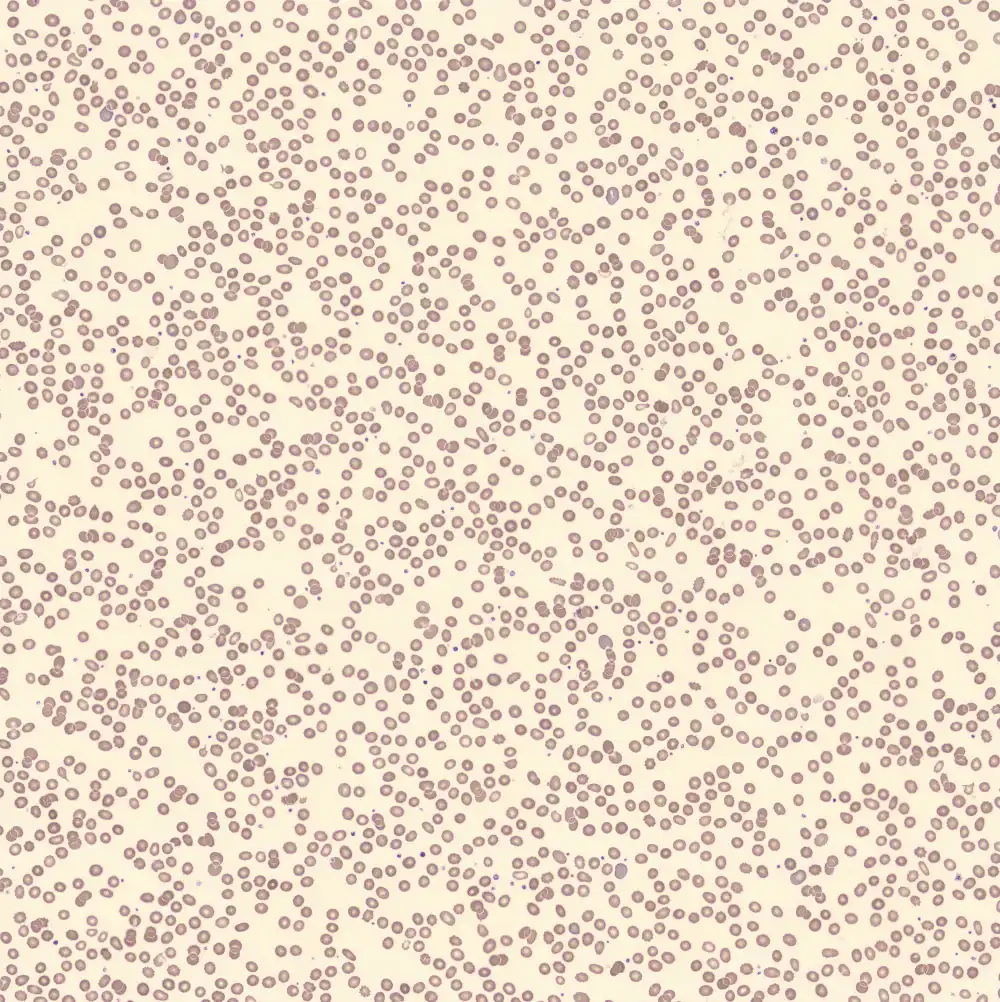
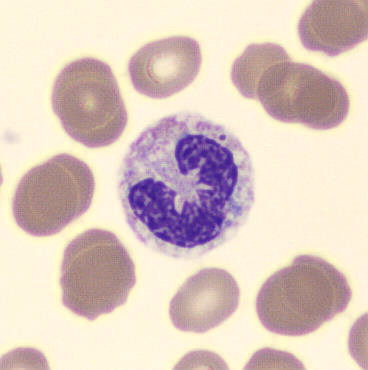
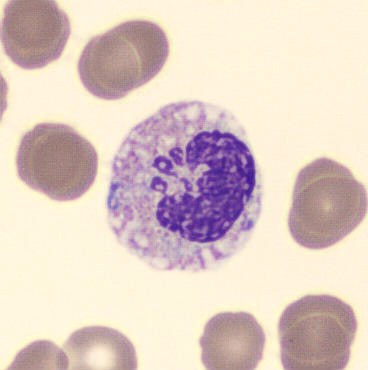
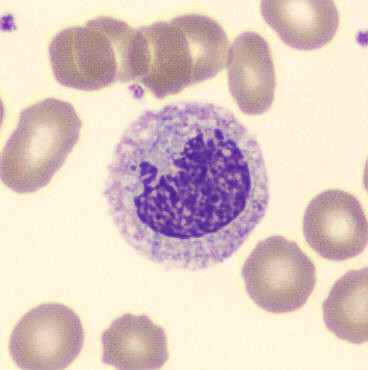
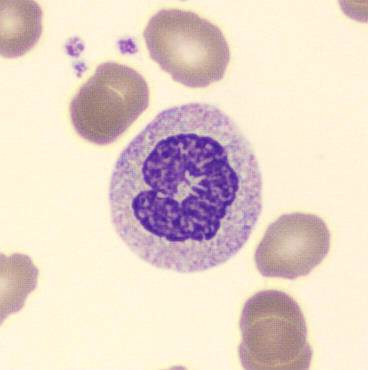
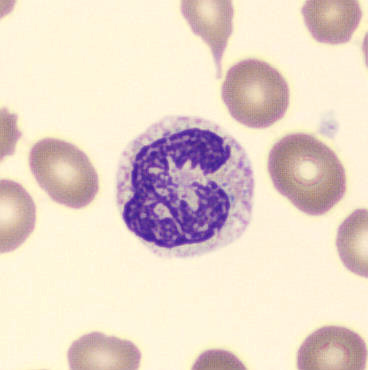
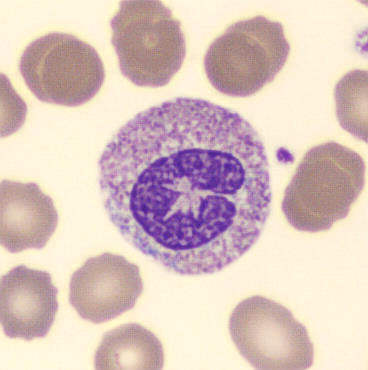
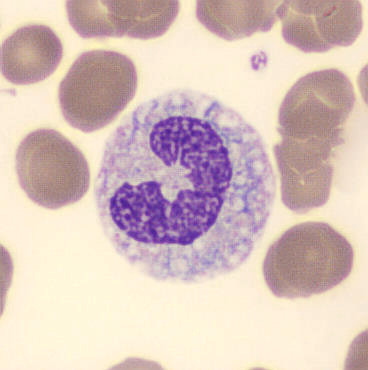
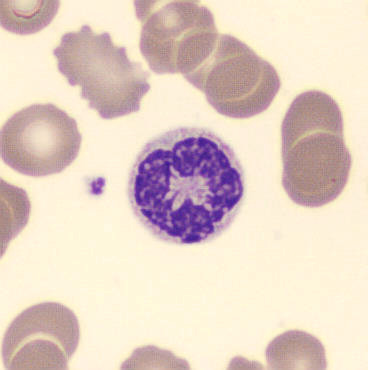
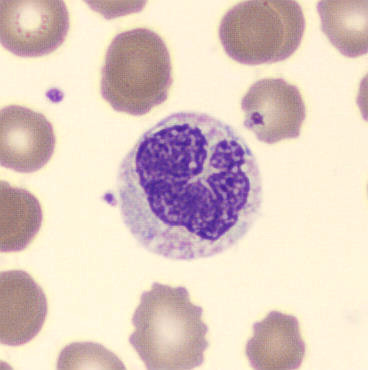
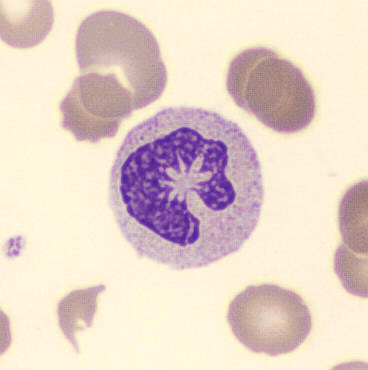
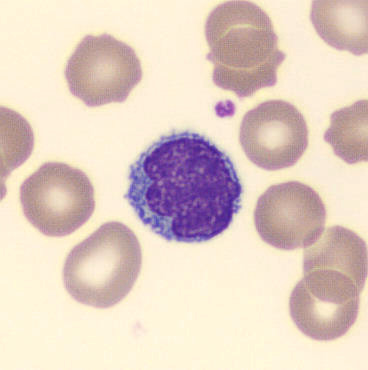
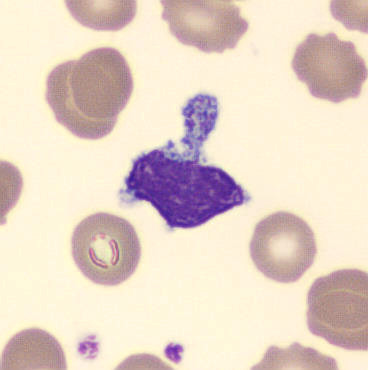
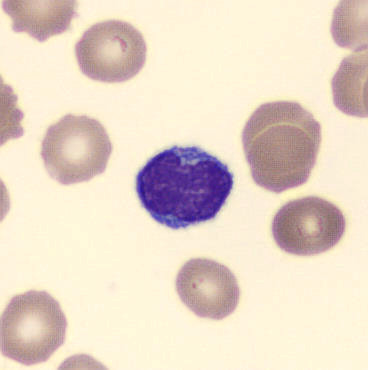
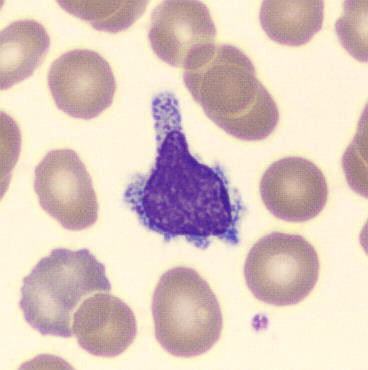
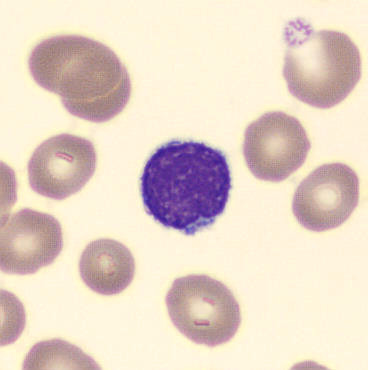
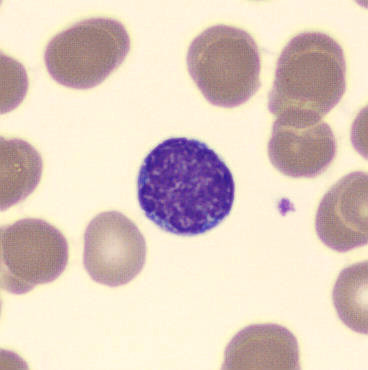
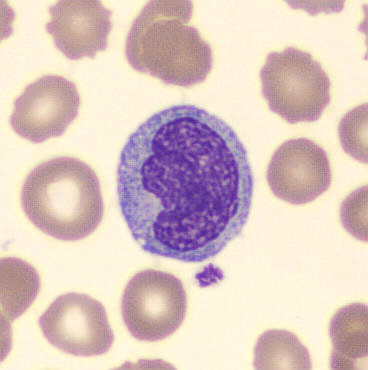
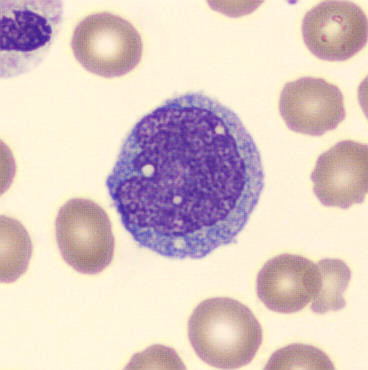

Tacrolimus - Objektträger 1
Synonyme: Prograf, Advagraf, Graceptor, Modigraf
Tacrolimus ist ein Immunsuppressivum, das die Produktion von T-Zellen durch Blockierung des Enzyms Calcineurin hemmt. Es wird häufig nach (Nieren-)Transplantationen verschrieben, um eine Abstoßung des Spenderorgans zu verhindern. Das Medikament wirkt sich nicht nur auf die Lymphozyten aus, sondern kann auch eine Dysplasie der neutrophilen Granulozyten verursachen.
Bei diesem Patienten, der sich einer Nierentransplantation unterzogen hat, sind neutrophile Granulozyten mit stark abnormaler Kernstruktur und Chromatin zu sehen.
Neutrophile
Lymphozyten
Monozyten
Eosinophile
Basophile
XN Scatterplots
Periphäres Blut
Neutrophilen

Lymphozyten

Monozyten